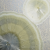
KD-001J (6).png

Lumea - Large ceramic urn - clear crystal glaze
Duża, ręcznie wykonana ceramiczna urna, która jest prawdziwym ucieleśnieniem elegancji, kunsztu i indywidualności. Ta urna to nie tylko naczynie pamięci, ale oszałamiające dzieło sztuki, zaprojektowane, aby uhonorować wyjątkowość życia ukochanej osoby z wdziękiem i ponadczasowym pięknem.
The photo is for illustrative purposes only. Due to the fact that each urn is entirely handmade, each one is a unique work of art. Subtle differences in the arrangement of the glaze and color nuances mean that the final appearance of the product may differ slightly from that shown in the photo, which contributes to its unique character.
Product code: KD-001J
Cechy produktu
- Material ceramika
- Dimensions (approximate) 19 (h) x 24 (w) cm
- Capacity (approx.) 3,8 l
- Weight 2 kg
- Suitable for powders up to body weight 106 kg
- Color white
Opis
A legacy of beauty
This urn from the Lumea collection is more than a memorial - it is a profound expression of love, memory and the timeless connection between art and the human spirit. Its handcrafted design, combined with mesmerizing crystal glazes and a harmonious color palette, ensures that it is a unique and elegant tribute to a loved one who is no longer with us. This urn is a breathtaking reminder of the beauty of a life well lived and the lasting legacy of those we cherish. It is not just an object; it is a masterpiece, a symbol of love and a celebration of the special moments that make every life extraordinary.
Each urn is meticulously, hand-formed on the potter's wheel, a process that gives it soul and craftsmanship. The potter's skilled hands shape the clay with precision, refining every curve and detail to achieve a flawless, harmonious form. The urn undergoes a multi-stage firing and glazing process, culminating in firing at high temperatures of up to 1,300°C. This ensures extreme durability, making the urn resistant to the passage of time and weather conditions. It is a testament to strength and durability, symbolizing the imperishable nature of love and memory. The urn is decorated with crystal glazes, made according to secret recipes that create mesmerizing, one-of-a-kind designs. These glazes are not only decorative; they tell a story, with each crystal formation symbolizing the uniqueness of the life being honored.
The glazing process results in an amazing play of bright colors, intermingling whites, delicate beiges and creams, which soothes the senses and induces a state of deep reflection. Shades of cream, white and light beiges, ranging from delicate cream to warm sand, symbolize peace, harmony and purity. These colors, enriched by soft reflections of light, create a depth and three-dimensional effect on the surface of the urn that delights and intrigues.
Kryształy w szkliwie są czymś więcej niż tylko wizualnym fenomenem - reprezentują ideę, że każde życie jest wyjątkowym, niezastąpionym klejnotem. Tak jak nie ma dwóch takich samych kryształów, tak nie ma dwóch identycznych urn w kolekcji Lumea, dzięki czemu każda z nich jest tak wyjątkowa, jak osoba, którą upamiętnia.
Wzornictwo urny stanowi idealne połączenie elegancji i niezwykłości. Wyrafinowane detale i wykwintne szkliwienie zapewniają, że pozostaje ponadczasowym hołdem. Jest to celebracja indywidualności, symbol wiecznej miłości i świadectwo trwałej mocy sztuki, która leczy i inspiruje.
Bezpieczeństwo produktu
Certificates and safety warnings
- For children 3 and over.
- Keep out of reach of children.
- Contains small parts that may be swallowed.
- Adult supervision recommended.
- Packaging is not a toy.
Responsible person in the EU
ZAFRA Marta Kalińska
Różana 37
62-045 Pniewy, Poland
Opinie
If you've added a review and it doesn't appear on the list, it may be pending moderation.